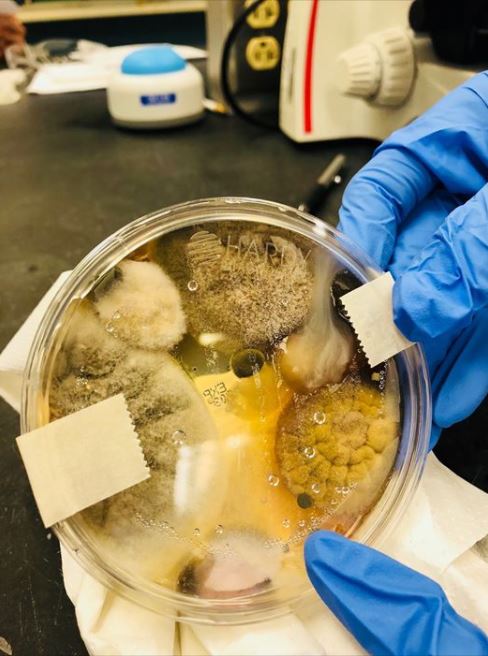
הצלחת המדוגמת לאחר 48 שעות

בפוסט שזכה למאות אלפי לייקים ושיתופים כתבה המדענית האמריקנית ניקול וורד, "אתם מוכנים לקבל את הידיעה שתסעיר לכם את הראש", וצירפה תמונה שבה מושבות של חיידקים ופטריות שדגמה ממייבש הידיים שכולנו מכירים מחדרי שירותים במקומות ציבוריים.
וורד, המשמשת כמדענית מקליפורניה, יצאה לבדוק האם הידיים אכן מתנקות לאחר שימוש במתקן למייבש האוויר שבשירותים, לשם כך השתמשה בצלחת ודגמה במשך שלוש דקות את האוויר הנפלט מהמייבש.
את הצלחת העבירה וורד למעבדה למשך זמן של 48 שעות וכששבה לבדוק את התרבית, נדהמה לגלות מושבות של מאות אלפי פטריות וחיידקים.
"זה מה שגדל בצלוחית הפטרי לאחר כמה ימים", כתבה וורד בפוסט שהפך לויראלי. המדענית הסבירה כי בצלחת הפטרי גדלו כמה זנים של חיידקים ופטריות, שככל הנראה מגיעים גם לידיים של מי שמייבש אותם במכשיר והוסיפה: "לעולם אל תייבשו את הידיים שלכם במייבשי הידיים האלה".
"השתמשתי במייבש ידיים כל כך הרבה פעמים, אבל מעכשיו אנער את הידיים באוויר. מייבשי האוויר מזוהמים ביותר, ובהם אתם מייבשים את ידיכם. אי אפשר לתאר מה שנמצא שם עד שדוגמים אותו במעבדה", כתבה המדענית וציינה כי המייבש שדגמה היה של חברת דייסון.
חברת האלקטורניקה דייסון שנכנסה לפאניקה מפרסום הבדיקה מיהרה להגיב: "הופתענו מהתוצאות, אך דרך הבדיקה אינה ברורה. כל מייבשי דייסון בעלי פילטרים שלוכדים חלקיקים קטנים כמו חיידקים מהאוויר לפני שהוא יוצא מהמכשיר. מחקרים אקדמיים הוכיחו כי מייבשי הידיים שלנו אמינים והיגיינים, ולא בכדי נמצאים גם בבתי חולים ובעסקים רבים ברחבי העולם".






0 תגובות